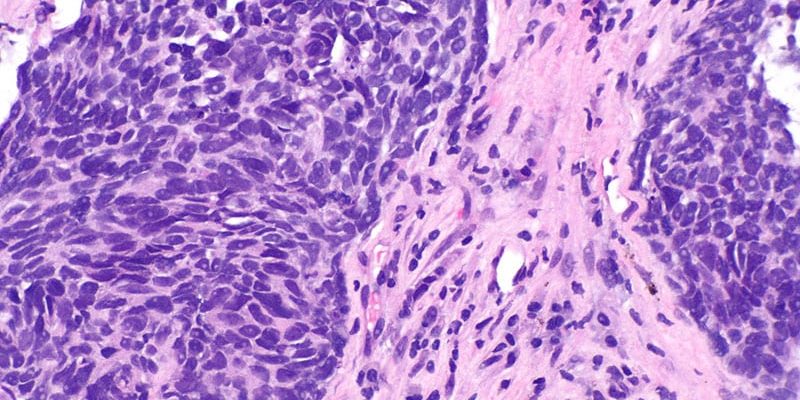
Der adaptive SABR-Boost ist bei fortgeschrittenem NSCLC vielversprechend

Montana-Gesetzgeber streiten sich mit dem Gesundheitsministerium des Staates über ein Paket weitreichender Änderungen an den Zulassungsregeln für Kinderbetreuung, zu denen auch eine umstrittene Bestimmung gehört, die Ausnahmen aus religiösen Gründen von Routineimpfungen für Kinder und ...
READ MORE +